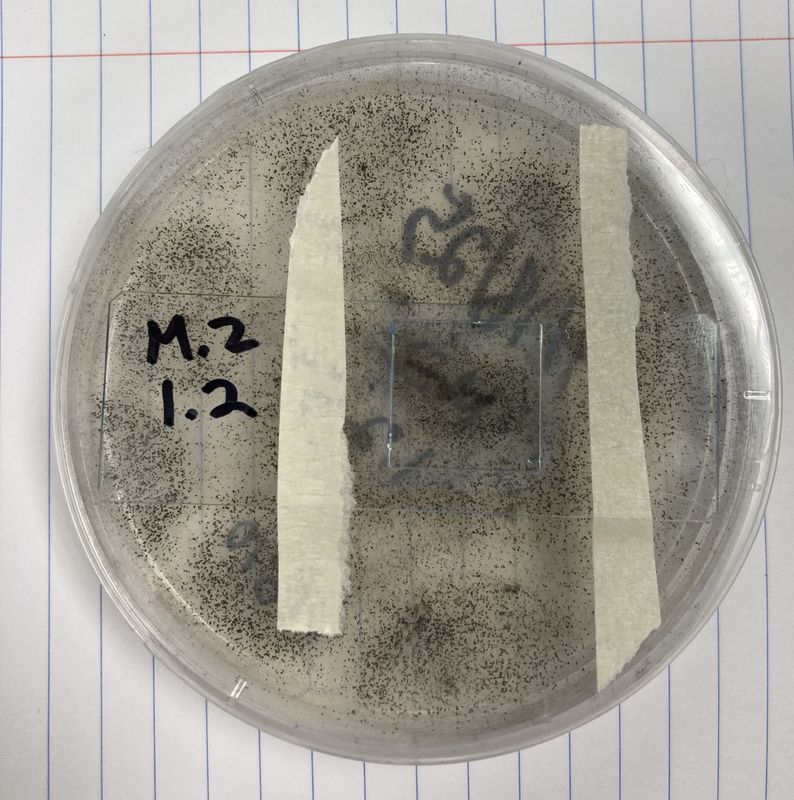

Occurrence May 9, 2025, 12:11 PM
Aspergillus niger
United StatesCaliforniaLos Angeles
Record
- Dataset
- iNaturalist Research-grade Observations
- Basis of record
- Human observation
Taxon
- Scientific name
- Aspergillus niger
- Taxon ID
- 350138
- Kingdom
- Fungi
- Phylum
- Ascomycota
- Class
- Eurotiomycetes
- Order
- Eurotiales
- Family
- Aspergillaceae
- Genus
- Aspergillus
- Rank
- species
Aspergillus niger Tiegh.
KingdomFungiPhylumAscomycotaClassEurotiomycetesOrderEurotialesFamilyAspergillaceaeGenusAspergillusSpeciesAspergillus niger
- Taxon ID not found
Aspergillus niger Tiegh.
DomainEukaryotaKingdomFungiPhylumAscomycotaClassEurotiomycetesOrderEurotialesFamilyAspergillaceaeGenusAspergillusSpeciesAspergillus niger
- Taxon ID not found
Location
- Continent
- North AmericaInferred
- Country or area
- United States of America
- State province
- California
- Verbatim locality
- Cal Poly Pomona, Pomona, CA, US
- Decimal latitude
- 34.057Coordinate roundedAltered34.0574305original
- Decimal longitude
- -117.826Coordinate rounded
- Coordinate uncertainty in metres
- 8
- Geodetic datum
- EPSG:4326
- Location according to GADM
- United StatesCaliforniaLos Angeles
Loading map...
Occurrence
- Occurrence ID
- Catalogue number
- 280139678
- Recorded by
- Mac Roni
- Sex
- Occurrence status
- PresentInferred
Other
- Record licence
- CC BY-NC 4.0Alteredhttps://creativecommons.org/licenses/by-nc/4.0/original
- Institution code
- iNaturalist
- Collection code
- Observations
- Dataset name
- iNaturalist research-grade observations
- Identifier
- 280139678
- Modified
- 2025-05-15T02:31:07Z
- References
- Rights holder
- Mac Roni
- GBIF ID
- 5153230006
Multimedia
- Format
- image/jpeg
- Identifier
- https://inaturali...4796/original.jpg
- References
- https://www.inatu.../photos/503114796
- Creator
- Mac Roni
- Publisher
- iNaturalist
- Rights holder
- Mac Roni
- Record licence
- http://creativecommons.org/licenses/by-nc/4.0/
- Created
- 2025-05-09T19:11:03Z
- Format
- image/jpeg
- Identifier
- https://inaturali...4739/original.jpg
- References
- https://www.inatu.../photos/503114739
- Creator
- Mac Roni
- Publisher
- iNaturalist
- Rights holder
- Mac Roni
- Record licence
- http://creativecommons.org/licenses/by-nc/4.0/
- Created
- 2025-05-09T19:11:03Z
- Format
- image/jpeg
- Identifier
- https://inaturali...4710/original.jpg
- References
- https://www.inatu.../photos/503114710
- Creator
- Mac Roni
- Publisher
- iNaturalist
- Rights holder
- Mac Roni
- Record licence
- http://creativecommons.org/licenses/by-nc/4.0/
- Created
- 2025-05-09T19:11:03Z
- Format
- image/jpeg
- Identifier
- https://inaturali...4719/original.jpg
- References
- https://www.inatu.../photos/503114719
- Creator
- Mac Roni
- Publisher
- iNaturalist
- Rights holder
- Mac Roni
- Record licence
- http://creativecommons.org/licenses/by-nc/4.0/
- Created
- 2025-05-09T19:11:03Z
- Format
- image/jpeg
- Identifier
- https://inaturali...4762/original.jpg
- References
- https://www.inatu.../photos/503114762
- Creator
- Mac Roni
- Publisher
- iNaturalist
- Rights holder
- Mac Roni
- Record licence
- http://creativecommons.org/licenses/by-nc/4.0/
- Created
- 2025-05-09T19:11:03Z
- Format
- image/jpeg
- Identifier
- https://inaturali...4726/original.jpg
- References
- https://www.inatu.../photos/503114726
- Creator
- Mac Roni
- Publisher
- iNaturalist
- Rights holder
- Mac Roni
- Record licence
- http://creativecommons.org/licenses/by-nc/4.0/
- Created
- 2025-05-09T19:11:03Z
Citation
- Please use this citation in publications
- iNaturalist contributors, iNaturalist (2025). iNaturalist Research-grade Observations. iNaturalist.org. Occurrence dataset https://doi.org/10.15468/ab3s5x accessed via GBIF.org on 2025-08-06. https://gbif.org/occurrence/5153230006
- API access
- Dataset
- iNaturalist Research-grade Observations
- Publisher
- iNaturalist.org
- Last crawled
- 2025-08-02T12:45:50.757